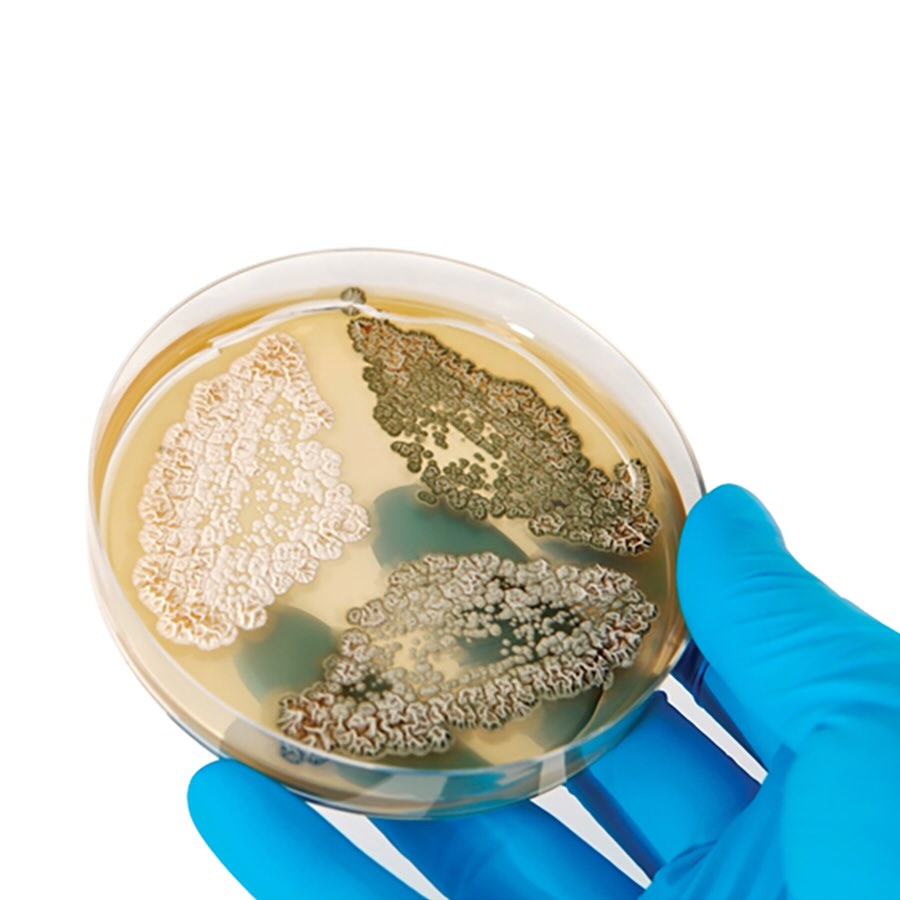
Stackable Petri Dish

S2K Commerce - Products Dropdown
S2K Commerce - Shopping Cart
S2K Commerce - Order Entry
Stackable Petri Dishes
Stackable Petri Dishes
Stackable Polystyrene Petri Dishes – Sterile & Disposable.
Explore our premium selection of stackable sterile petri dishes, engineered for general microbiological use, pharmaceutical testing, and environmental monitoring. Molded from optically clear medical-grade virgin polystyrene, these dishes are radiation sterilized and individually traceable for quality assurance.
Available in multiple configurations, standard mono, bi-plate, tri-plate, quad-plate, and deep-well, our petri dishes are designed for performance, safety, and convenience in any lab setting.
Choose the right size and format to meet your specific testing needs.
Key Features
- Sterile, single-use polystyrene for contamination-free experiments
- Stackable design with ventilation ribs to reduce condensation
- Clear top and bottom surfaces for optimal sample visibility
- Consistent flatness ensures even media distribution
- Radiation sterilized - sterile until sleeve is opened
- Compartments for easy organism differentiation (1, 2, 3, and 4 compartment models)
- Flared lid skirts & squared corners for one-hand operation, even with gloves
Specifications
| Item # | Diameter | Height | Compartments | Type | Features | Iso Mark | Sterility |
| 901 | 60 mm | 15 mm | 1 | Stackable | Media Saver | No | Sterile |
| 900 | 100 mm | 15 mm | 1 | Stackable | Industry Standard | No | Sterile |
| 906 | 100 mm | 25 mm | 1 | Stackable | Extra Deep Dish | No | Sterile |
| 903 | 100 mm | 15 mm | 2 | Stackable | 2 Compartments | No | Sterile |
| 912 | 100 mm | 15 mm | 3 | Stackable | 3 Compartments | No | Sterile |
| 913 | 100 mm | 15 mm | 4 | Stackable | 4 Compartments | No | Sterile |
Proudly made in the USA! Click here for more made in America products!

| SKU Number | Size | Compartment | Type | Sterility | Qty | Price | Quantity | Add to Cart |
| 901 | 60 x 15 mm | 1 | Stackable | Sterile | 20/pk, 25 pks/cs |
140.00
Each
|
||
| 900 | 100 x 15 mm | 1 | Stackable | Sterile | 25/pk, 20 pks/cs |
167.00
Each
|
||
| 906 | 100 x 25 mm | 1 | Stackable | Sterile | 17/pk, 20 pks/cs |
169.00
Each
|
||
| 903 | 100 x 15 mm | 2 | Stackable | Sterile | 25/pk, 20 pks/cs |
195.00
Each
|
||
| 912 | 100 x 15 mm | 3 | Stackable | Sterile | 25/pk, 20 pks/cs |
195.00
Each
|
||
| 913 | 100 x 15 mm | 4 | Stackable | Sterile | 25/pk, 20 pks/cs |
195.00
Each
|

Web Content Viewer